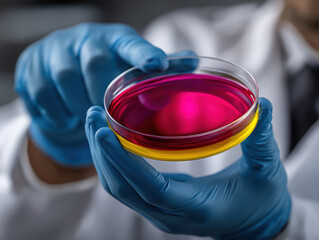
Scientist holds petri dish with colorful liquid in laboratory setting

- Home >
- Stock Photos >
- Senior Scientist Analyzing Data in Advanced Lab
Senior Scientist Analyzing Data in Advanced Lab Image

Caucasian male scientist in a laboratory is interfacing with virtual data displays, symbolizing advancement in research and technology. Ideal for illustrating concepts related to scientific exploration, technological innovation, and digital data analysis in journals, educational materials, and science tech discussions.
downloads
Tags:
More
Credit Photo
If you would like to credit the Photo, here are some ways you can do so
Text Link
photo Link
<span class="text-link">
<span>
<a target="_blank" href=https://pikwizard.com/photo/senior-scientist-analyzing-data-in-advanced-lab/aaeb24eb69f01b24c5a3dfe30603f67b/>PikWizard</a>
</span>
</span>
<span class="image-link">
<span
style="margin: 0 0 20px 0; display: inline-block; vertical-align: middle; width: 100%;"
>
<a
target="_blank"
href="https://pikwizard.com/photo/senior-scientist-analyzing-data-in-advanced-lab/aaeb24eb69f01b24c5a3dfe30603f67b/"
style="text-decoration: none; font-size: 10px; margin: 0;"
>
<img src="https://pikwizard.com/pw/medium/aaeb24eb69f01b24c5a3dfe30603f67b.jpg" style="margin: 0; width: 100%;" alt="" />
<p style="font-size: 12px; margin: 0;">PikWizard</p>
</a>
</span>
</span>
Free (free of charge)
Free for personal and commercial use.
Author: Awesome Content